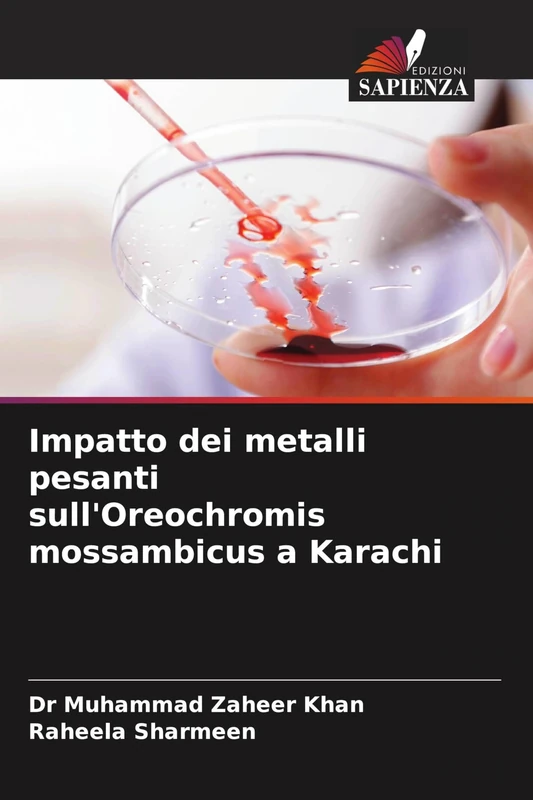
Impatto dei metalli pesanti sull'Oreochromis mossambicus a Karachi

We can't find the internet
Attempting to reconnect
Something went wrong!
Hang in there while we get back on track

£61.00
Inquinamento dell'acqua dolce e rimozione dei metalli pesanti
Price data last checked 95 day(s) ago - refreshing...
We'll watch every seller, every day. One email when your price arrives.
It has never been this cheap. We have no record of a lower price.
£61 today · cheaper than every other day in the last 6 months
NEW HERE?
Amazon shows you one price. We show you all of them.
Tosheroon watches Amazon prices so you don't have to. Every product on Amazon has a price history — we make it visible. Set the price you'd actually pay, and we'll email you the second it gets there. No app, no account, one email.
WHAT'S ON THIS PAGE
when this has been cheap or pricey
where the price is heading next
all-time high & low, recent range
name your number, we'll email you
Price History & Forecast
Grey patches = out of stock. Cheaper = lower on the chart. Hover for exact prices.
Last 91 days • 91 data points (No recent data available)
Price Distribution
Price distribution over 91 days • 1 price levels
Price Analysis
Most common price: £61 (91 days, 100.0%)
Price range: £61 - £61
Price levels: 1 different prices over 91 days
Product Specifications
- Format
- paperback
- ASIN
- 6206875067
- Domain
- Amazon UK
- Release Date
- 27 November 2023
- Listed Since
- 28 November 2023
Barcode
No barcode data available
Similar Products You Might Like

Mobilitare il potere delle persone e dei media: Igiene e sanificazione dell'acqua potabile

Sensibilizzazione ambientale per il riutilizzo delle acque grigie

Trattamento chimico dell'acqua prodotta per ridurre i danni alla formazione

Rilevamento e caratterizzazione di alcuni batteri patogeni nell'acqua

Indagine sullo smaltimento di sostanze pericolose nelle acque reflue industriali: Trattamento con nanotecnologie

Inquinamento del suolo: Suolo, contaminazione e biorisanamento del suolo

Rimozione di inquinanti dalle acque reflue mediante nanofibre composite: Trattamento delle acque reflue con nanofibre composite

Riciclo delle acque reflue industriali: conservazione dell'acqua nella setta dell'energia solare

Fitorimedio dei metalli pesanti utilizzando L. leucocephala

Qualità dell'acqua e prevalenza delle infezioni parassitarie nel lago Burullus
Impatto dei metalli pesanti sull'Oreochromis mossambicus a Karachi

Analisi statistica dei parametri di qualità dell'acqua

Tecniche di intelligenza artificiale: Risorse idriche e cambiamento climatico

Scambiare l'ambiente: accettare una compensazione per i rischi pubblici

Riabilitazione aziendale e fallimento transfrontaliero nel diritto brasiliano: Ristrutturazione aziendale e insolvenza

Discrepanza antero-posteriore: Daignosi e trattamento

Biomarcatori: diagnosi precoce degli ambienti acquatici

Gli effetti di piombo, cadmio, mercurio e arsenico sui pesci

Piacere dello shopping e acquisti impulsivi online

Otturatori Per Difetti Mascellari

Futuro sostenibile: Energia rinnovabile e idrogeno

Il Bio-Rimediatore: La proliferazione dei nanomateriali e il biorisanamento ambientale

Assorbimento dell'acqua nei compositi di fibre naturali: Sfide e progressi
